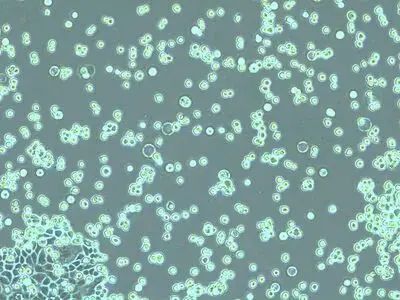
分离出的细胞应呈圆形并在胰蛋白酶溶液中自由漂浮

如何对细胞培养进行快速正确的检测
发布时间:2026-01-04 浏览次数:2782

本文介绍了对培养贴壁细胞系进行传代的一般工作流程及步骤说明。哺乳类细胞体外培养是在癌症、药物开发、组织工程、干细胞、疾病细胞和分子生物学等生物医学研究领域进行临床和药物研究的重要模型。要想成功维持细胞系,需要通过控制生长条件来维持细胞生理和表型的稳定性。定期监测细胞生长,对细胞进行传代培养以确保连续性。
背 景
哺乳类细胞培养对临床和药物研究与应用至关重要,其可用于构建灵活的健康和疾病模型系统。例如在机能研究可支持电脑模拟分析并可用于替代动物模型。
细胞增殖取决于细胞类型(从动物组织分离的原代细胞、胚胎干细胞、自我更新细胞、稳定永生化细胞系、转化细胞)和培养条件(培养基、2D/3D细胞外基质、温度、PH值、CO2/O2浓度)。在最佳培养条件下可以培养出用于各种实验分析的细胞。随着动物细胞培养技术的进步,细胞系逐步演变并被用于疫苗生产、治疗性蛋白、药物制剂和抗癌制剂。
要想成功维持哺乳类细胞系,必须在受控条件下培养细胞并使用特定培养基。此外,为保证细胞生理和表型的稳定性,必须定期监测细胞生长状况。通常情况下,当细胞汇合度达到80%左右,须对细胞进行传代培养,以确保细胞生长良好且健康。细胞汇合度达80%指的是培养皿80%的表面被细胞所覆盖。注意:传代培养细胞的最佳汇合度取决于细胞类型且可能还需优化。
本篇文章描述了传代培养贴壁细胞系的一般工作流程并附上步骤说明和详细图解(见图2)。
为何需要对细胞进行传代?
培养的细胞不可能无限生长,原因在于在有限的空间内细胞数量不断增多,营养物质消耗,有毒代谢物增多最终导致细胞死亡。此外,研究人员通常需要重复实验,因此需要对培养细胞进行削减或扩增。经过传代后细胞能生成相比原先密度更低的新细胞。去掉旧的培养基,将细胞转移至新鲜培养基和基质中,补充新鲜营养物质并清除有毒代谢物能够长期维持培养细胞。一开始接种细胞后,细胞生长进入迟滞期然后是对数生长期,此时细胞呈指数增殖,接着进入静止期,此时细胞生长率和死亡率持平。(见图1)。进入衰亡期,细胞因缺乏营养物质或培养条件不充足而死亡,例如细胞因汇合度过高开始争夺生存空间。

图1:细胞生长曲线:培养细胞的生长曲线包含四个阶段:生长开始前的潜伏期(迟滞期)、指数增长期(对数生长期)、静止期(细胞增殖速度逐渐减慢)、衰亡期(细胞因缺乏营养物质以及生存环境有问题而死亡)。应在对数生长期更换培养基并在进入静止期前对细胞进行传代培养。
要使细胞处于最佳培养条件且维持活跃增长,有必要更新培养基并定期进行传代培养。可根据细胞类型在对数生长期多次更换培养基。传代培养的最佳时间位于对数生长期和静止期之间,在细胞达到密集状态前进行。
为何需要检查细胞?
每日以及在传代培养前检查细胞培养物非常重要,以此监测细胞健康状况、检查污染情况、确定细胞分离时间。首先用肉眼检查培养基中是否出现真菌污染、培养基浑浊度和颗粒情况,以及通过培养基的颜色变化发现意外的pH值变化。首先用肉眼检查培养基中是否出现真菌污染、培养基浑浊度和颗粒情况,以及通过培养基的颜色变化发现意外的pH值变化。之后应使用倒置显微镜近距离检查细胞整体形态和生长模式。倒置显微镜的光学元件位于样本下方。由于细胞附着在培养皿底部,从底部视角便于观察。由于正常明场照明下难以观察到大多数细胞,因此应在100至200倍的总放大倍数和相差下进行观察[1]。
哺乳类细胞有很多种形态,但培养出的哺乳类细胞大多可分为3类:成纤维细胞【中国仓鼠卵巢(CHO)细胞】、上皮样细胞【人类子宫颈(HeLa)细胞】以及淋巴样细胞【人类白血病(HL60)细胞】。此外,某些细胞系具有特定的形态特征,例如神经细胞(SH-SY5Y)具有很长的树突。细胞形态还受细胞生命周期活动影响。在有丝分裂过程中,许多细胞变得更圆,形成可在培养基中漂浮的高折射性发亮球体。死亡细胞的细胞膜完整性发生变化,细胞变得更圆,贴壁细胞从生长表面分离。在显微镜下,死亡细胞通常不会发亮及产生折射,它们通常的细胞膜形态可能会发生改变
不同细胞系不仅尺寸和形状不同,生长特性也有所不同。它们要么发展成贴壁细胞(成纤维细胞和上皮细胞),要么发展成悬浮细胞(淋巴样细胞)。大多数贴壁细胞系会生成单细胞层,附着在玻璃或经处理的塑料基板上(例如涂有聚赖氨酸、纤连蛋白、胶原蛋白或明胶)。
如何传代培养细胞?
最常见的传代细胞制备方法是使用胰蛋白酶等蛋白水解酶分解细胞间及细胞与培养基之间的黏合。胰蛋白酶和乙二胺四乙酸的共同作用使细胞从生长表面脱离。胰蛋白酶切断将细胞固定在培养皿上的黏着斑,乙二胺四乙酸则作为钙螯合剂。
根据细胞类型或下游实验也可使用其他蛋白酶代替胰蛋白酶,如天然胶原酶或合成消化鸡尾酒溶液等。
将参与细胞间相互作用的钙粘蛋白中的钙成分去掉,从而分解钙粘蛋白,将细胞分离开来。细胞一旦失去与生长表面和周围细胞的黏合,就能轻易分离并在新的细胞培养皿中生长。细胞一旦失去与生长表面和周围细胞的黏合,就能轻易分离并在新的细胞培养皿中生长。图2描述了传代培养工作流程的基本步骤。在整个传代培养过程中重要的是,要在无污染环境下工作。在传代培养初始阶段、胰蛋白酶分解过程中、细胞计数环节以及细胞分离后都要检查细胞状况。保持正确记录和归档对于获得一致结果和实验追溯同样非常重要。

图2:传代培养工作流程中标红的步骤表示需要使用显微镜检查。
以下实验计划给出了狗肾脏细胞在90mm有盖培养皿中进行传代培养的基本原则。这些细胞是从狗的远端小管上分离的上皮细胞。在培养过程中,细胞贴壁生长,在实现汇合后形成由多边形细胞构成的单细胞层。
需要以下材料和设备:
材料:
▪ 培养基预热至 37° C(狗肾脏细胞需要:MEM培养基加5%FCS胎牛血清、2mM谷氨酰胺、100 U/mL青霉素、100 mg/mL链霉素);
▪ 预热不含钙镁的PBS缓冲液;
▪ 在D-PBS缓冲液中预热0.05%的胰蛋白酶、0.02%的乙二胺四乙酸;
▪ 台盼蓝(活体染剂);以及消毒用的70%乙醇或异丙醇。
当进行无动物源或成分明确的细胞培养时,使用无血清培养基、FBS/FCS合成替代品及非动物性解离剂。
材料:
▪ 带一次性吸头的细胞计数室移液管或微量移液管;
▪ 支持相差功能的倒置显微镜(DMi1,Mateo TL);
▪ 防护服和材料;
▪ 温度适宜的水浴槽;
▪ 37°C、含5% CO2、湿度高的培养箱;
▪ 离心机;
▪ 离心管;
▪ 事先标注的培养皿。
狗肾脏细胞的传代比例应为1:10。根据细胞类型调节比例。例如原代细胞培养物、永生化细胞系、胚胎干细胞等可能具有不同的最佳比例。
使用徕卡DMi1传代培养贴壁细胞的4步工作流程
步骤1
细胞检查
从培养箱中取出细胞并放在显微镜下快速检查。应每天进行显微镜检查,确保细胞处于健康状态(无污染、死亡细胞少)并按预计生长。

在培养贴壁细胞时,细胞应主要附着在培养皿活烧瓶底部,培养基应呈粉橙色。由于培养基中细胞代谢物(或污染)导致酸化,因此酸碱指示剂酚红呈黄色。由于培养基中细胞代谢物(或污染)导致酸化,因此酸碱指示剂酚红呈黄色。在正常明场照明下难以观察到这些细胞。切换至相差可以使细胞更容易被观察到。如图所示,使用DMi1,只需移动聚光镜环的滑块即可选择相差。
记录细胞状态对确保各实验结果一致十分重要。DMi1可配备摄像头和屏幕,通过远程控制轻松实现成像和保存。研究人员使用Mateo TL集成摄像头可以拍摄细胞图像,追踪培养基状况,将图像转存智能设备或U盘。

比较狗肾脏细胞在明场照明和相差图像中的显示效果:相差图像的概览效果更好,更易于检查细胞形态和细胞计数。

步骤2
细胞提取
用移液器将培养基吸取至废物容器中。也可以使用接有真空吸液器的移液器。

使用5ml不含钙镁的预热PBS缓冲液仔细冲洗细胞,冲洗3次,去除残留培养基中的胎牛血清。胎牛血清及其替代物会抑制胰蛋白酶。加入3ml预热胰蛋白酶/乙二胺四乙酸,轻轻转动培养皿使其均匀覆盖培养皿底部的细胞。在37°C下培育几分钟即可传代细胞。

不同细胞系需要的胰蛋白酶培养时间不同。为避免过度胰蛋白酶化使细胞受损,每隔几分钟在显微镜下检查一次细胞。

轻柔地冲洗培养皿,并将细胞悬浮液转移至50ml试管中,以800rpm的速度转动5分钟使细胞沉降下来。吸走上层清液并在10ml新鲜培养基中重悬细胞,彻底去除胰蛋白酶。

分离出的细胞应呈圆形并在胰蛋白酶溶液中自由漂浮。细胞一经分离,即向培养皿中加入5ml培养基,灭活胰蛋白酶。
步骤3
细胞计数
将100µL细胞悬浮液与等量的0.4%台盼蓝溶液混合。台盼蓝选择性渗入死亡细胞的细胞膜并将其染蓝,但不会被活细胞吸收。将盖玻片置于计数表面上,准备好血球计。

将移液器吸嘴置于盖玻片边缘轻轻挤出细胞悬浮液,将其滴加在计数室上(单位面积约4µl)。盖玻片下的整片区域发生毛细管作用。大多数情况下,计数室有两个计数区可各自承接液体。

将计数室放在显微镜载物台上并将焦点集中在细胞上。方形计数网格样式依计数室类型而定。图中所示的Fuchs-Rosenthal血细胞计数板有16个区域,每个区域1平方毫米,整体被线包围。每个正方形区域被细分为16个小正方形。如图所示,计算一个区域内16个正方形中的细胞总数。为避免重复计算位于大正方形边线上的细胞,仅计算位于正方形两条边上的细胞。在本例中,触及正方形上方和左侧标红边线(加粗红线)的细胞应被计入。触及下方和右侧红色边线的细胞应不被计入。计算计数室5个1平方毫米区域内的活细胞和死亡细胞。要计算最终结果,需要合计5个正方形的计数结果。为求得更精确的测算结果,也可以计算计数室其他正方形(大于5个)的细胞数量。
使用以下公式可计算细胞浓度:

此外还可使用细胞自动计数器。

步骤4
细胞植入
用移液器将所需细胞量(合适的细胞数量)以所需分离率(此处为1:10)吸取至新的培养皿中,在各培养皿中加入所需容积的培养基(10ml)。注意细胞类型、细胞分离日期以及培养皿盖子上的细胞传代次数。将细胞放回37°C培养箱中。

将细胞放置一晚,让其恢复和沉降。24小时后使用显微镜检查细胞形状、黏着性及是否存在污染。

细胞应附着在培养皿底部并已开始生长和分裂。细胞应附着在培养皿底部并已开始生长和分裂。让细胞生长直至汇合并准备好进入实验或开始下一轮传代培养。

参考文献:
1.W. Ockenga, Phase Contrast: Making Unstained Phase Objects Visible, Science Lab (2011) Leica Microsystems.
说明:文章来源“科尔德”公众号,转载只为分享目的,如有侵权或不愿小编转载发布请联系删除,谢谢!












